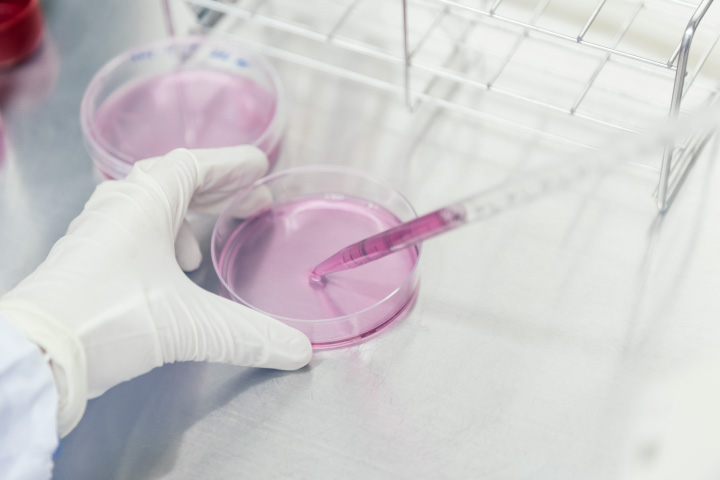

Overview
Name
Denka Company Limited
Directory
Established
May 1,1915
Paid-in Capital
¥36,998 Million
Business Portfolio
- ・Electronics & Innovative Products
- (Acetylene Black, Functional Ceramics, Films & Tapes, Thermally Conductive Substrates & Materials, Adhesive etc…)
- ・Life Innovation
- (Influenza Vaccine, Antigen Testing Kits etc…)
- ・Elastomer & Infrastructure Solutions
- (Functional Elastomer, Special Cement Additives, Fertilizer, Corrugated Pipe, Alumina Fiber etc...)
- ・Polymer Solutions
- (Styrene-Based Performance Plastics, Acetyl Chemicals, Synthetic Fiber, Food Packaging Materials etc…)
Employees
6,454 (Consolidated) 4,234 (Non-Consolidated)
Market
Tokyo Stock Exchange Prime Market (Code:4061)